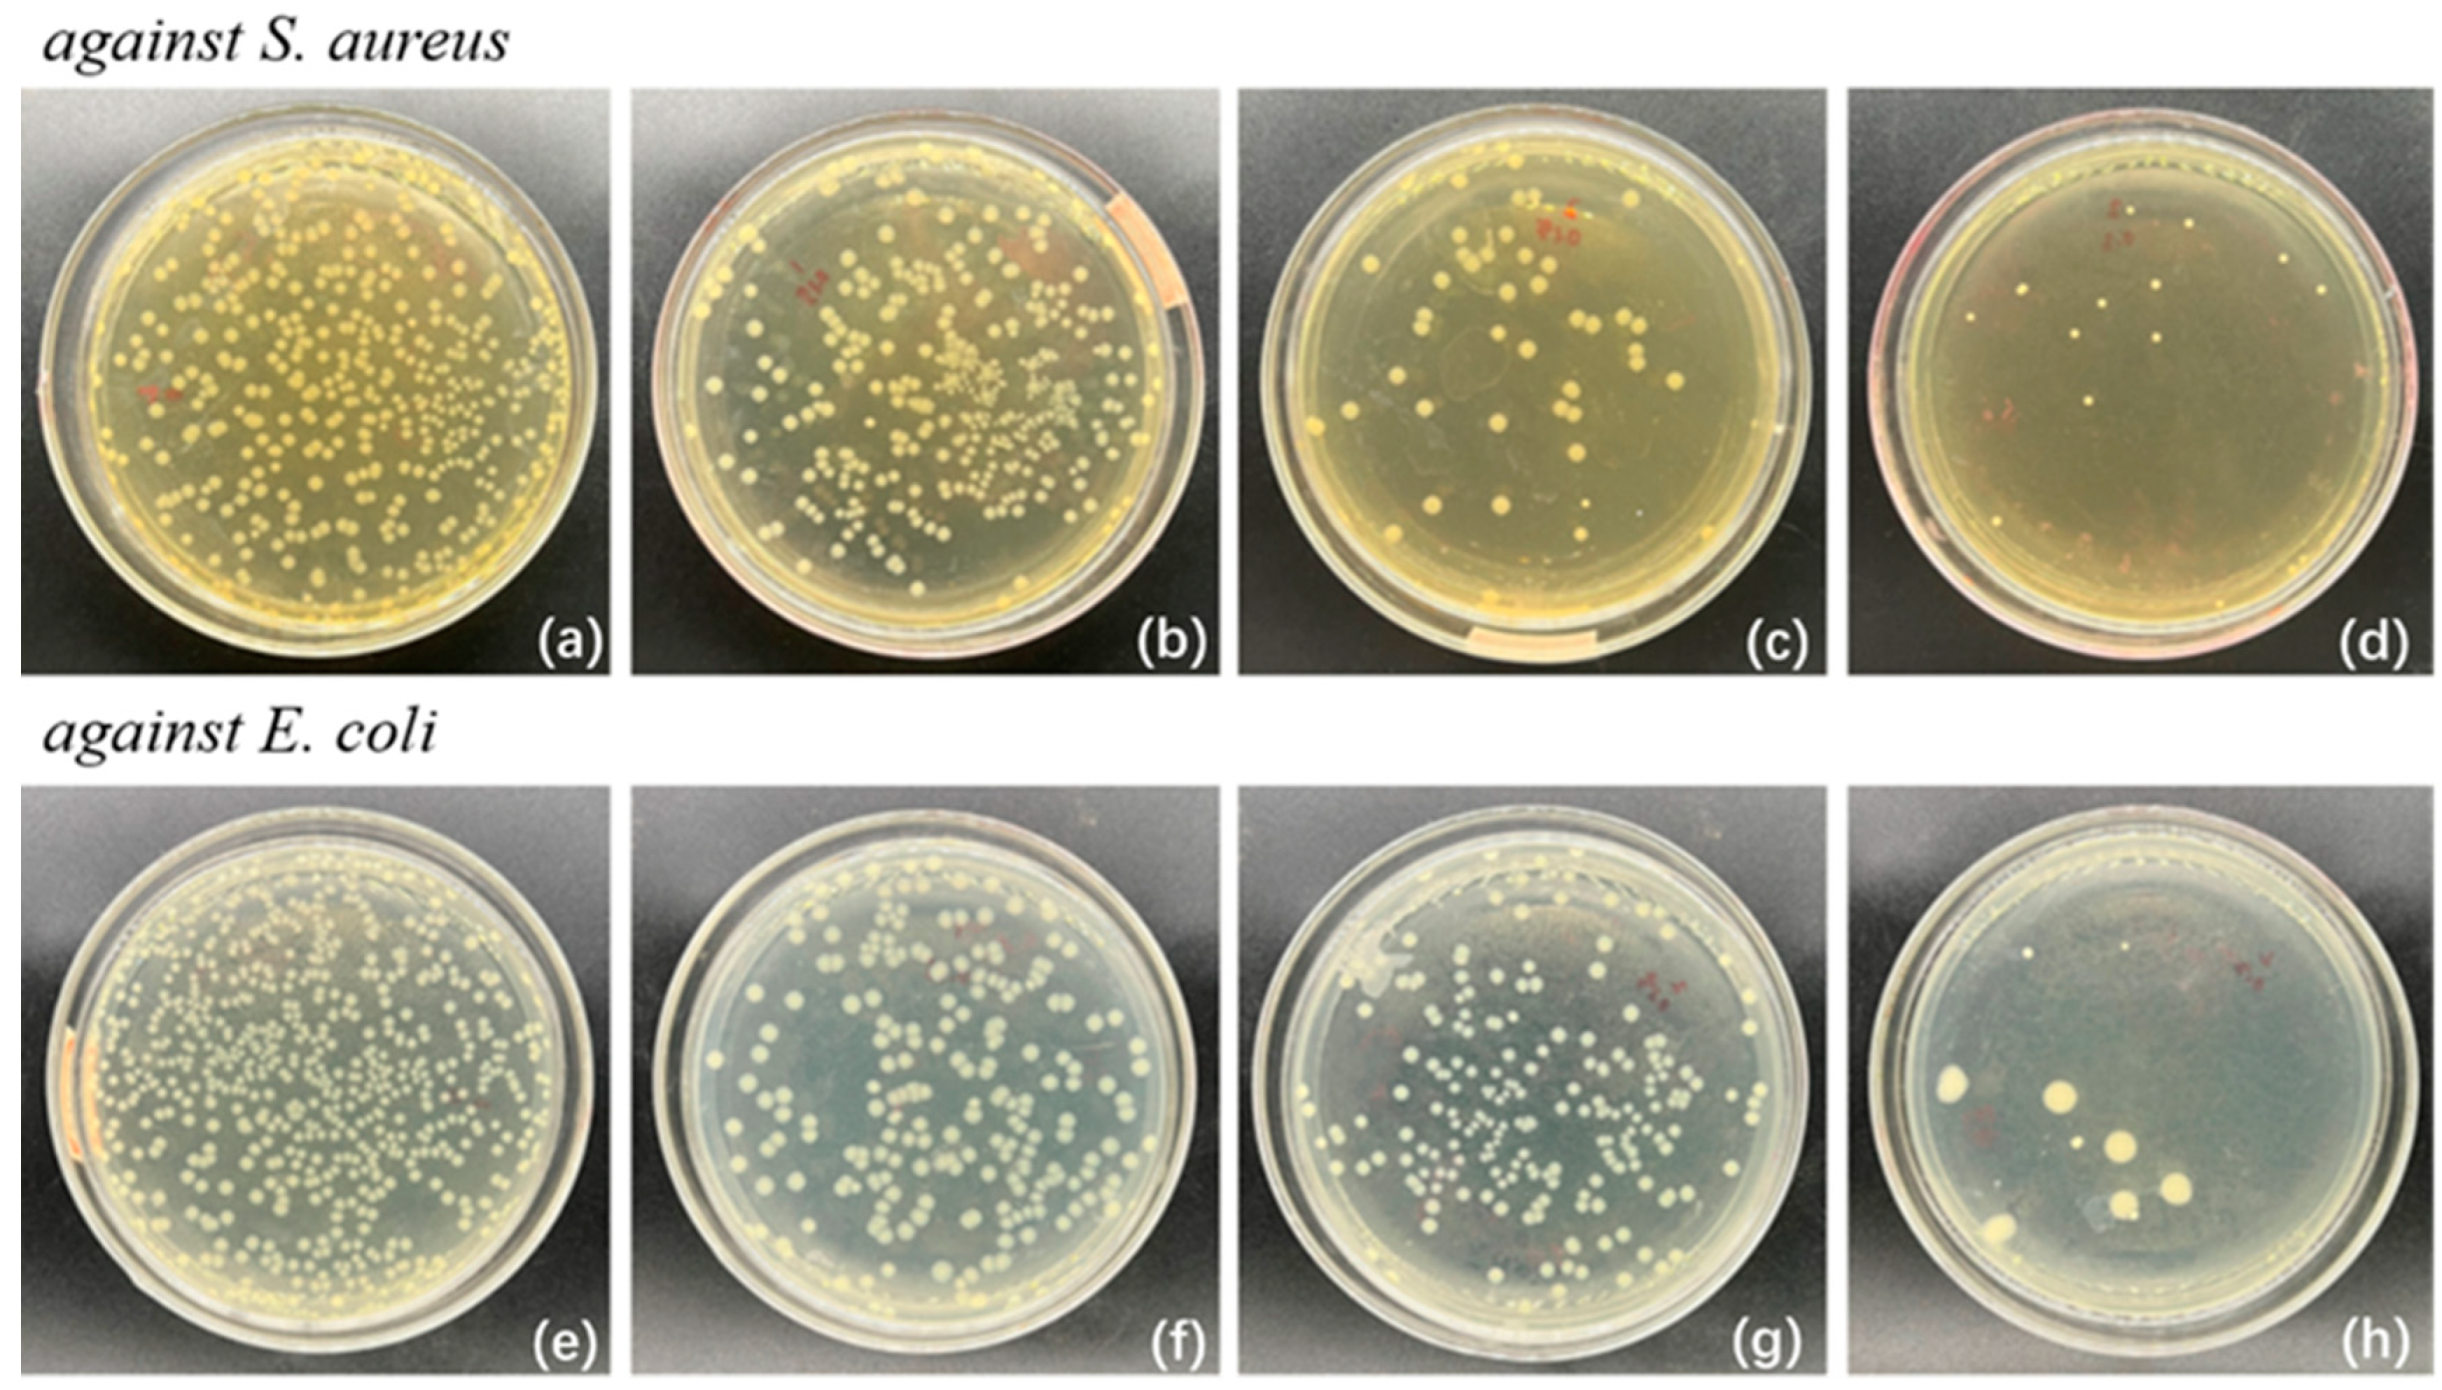
Polymers 17 01144 g005

Cinnamon Essential Oil-Loaded Halloysite Nanotubes Applied in Degradable Film: Characterization and Non-Contact Antimicrobial Activity
Abstract
1. Introduction
2. Materials and Methods
2.1. Materials
2.2. Preparation of CEOs/HNTs Nanoparticles
2.3. Processing of CEOs/HNTs/PBAT Biodegradable Films
2.4. Characterization
2.4.1. FT-IR Analysis
2.4.2. The Content of CEOs in Nanoparticles During the Different Storage Periods
2.4.3. Field Emission Scanning Electron Microscope (FE-SEM)
2.4.4. Transmittance and Barrier Properties of the Films
2.4.5. Mechanical Properties
2.4.6. Antimicrobial Activity of the Films
2.4.7. Inhibition Zone of the Nanoparticles Experiment
2.4.8. Assay of Strawberry Packaging
3. Results and Discussion
3.1. FT-IR Spectroscopy
3.2. Essential Oil-Loading and Retention Analysis
3.3. FE-SEM Analysis of Nanoparticle
3.4. The Property Analysis of Films
3.5. Analysis of Antibacterial Activity of Composite Films
3.6. Analysis of the Non-Contact Bacteriostatic Zone of Antibacterial Particles
3.7. Freshness Preservation Applications of the CEOs/HNTs/PBAT Biodegradable Films
4. Conclusions
Supplementary Materials
Author Contributions
Funding
Institutional Review Board Statement
Data Availability Statement
Conflicts of Interest
References
- Vahedikia, N.; Garavand, F.; Tajeddin, B.; Cacciotti, I.; Jafari, S.M.; Omidi, T.; Zahedi, Z. Biodegradable zein film composites reinforced with chitosan nanoparticles and cinnamon essential oil: Physical, mechanical, structural and antimicrobial attributes. Colloids Surf. B Biointerfaces 2019, 177, 25–32. [Google Scholar] [CrossRef] [PubMed]
- Hasanin, M.S.; Youssef, A.M. Ecofriendly bioactive film doped CuO nanoparticles based biopolymers and reinforced by enzymatically modified nanocellulose fibers for active packaging applications. Food Packag. Shelf Life 2022, 34, 100979. [Google Scholar] [CrossRef]
- Wang, Y.; Yang, H.; Li, B.; Liu, S.; He, M.; Chen, Q.; Li, J. Poly(Butylene Adipate/Terephthalate-Co-Glycolate) Copolyester Synthesis Based on Methyl Glycolate with Improved Barrier Properties: From Synthesis to Structure-Property. Int. J. Mol. Sci. 2022, 23, 11074. [Google Scholar] [CrossRef]
- Huang, T.; Qian, Y.; Wei, J.; Zhou, C. Polymeric Antimicrobial Food Packaging and Its Applications. Polymers 2019, 11, 560. [Google Scholar] [CrossRef]
- Arrais, A.; Manzoni, M.; Cattaneo, A.; Gianotti, V.; Massa, N.; Novello, G.; Caramaschi, A.; Gamalero, E.; Bona, E. Host–Guest Inclusion Complexes of Essential Oils with Strong Antibacterial and Antifungal Features in Beta-Cyclodextrin for Solid-State Pharmaceutical Applications. Appl. Sci. 2021, 11, 6597. [Google Scholar] [CrossRef]
- Zheng, H.; Wang, J.; You, F.; Zhou, M.; Shi, S. Fabrication, Characterization, and Antimicrobial Activity of Carvacrol-Loaded Zein Nanoparticles Using the pH-Driven Method. Int. J. Mol. Sci. 2022, 23, 9227. [Google Scholar] [CrossRef]
- Kim, J.; Yoon, C.S.; Na, J.H.; Han, J. Prolonged insecticidal activity of clove oil-loaded halloysite nanotubes on Plodia interpunctella infestation and application in industrial-scale food packaging. J. Food Sci. 2019, 84, 2520–2527. [Google Scholar] [CrossRef]
- Lee, M.H.; Seo, H.S.; Park, H.J. Thyme oil encapsulated in halloysite nanotubes for antimicrobial packaging system. J. Food Sci. 2017, 82, 922–932. [Google Scholar] [CrossRef]
- Chuesiang, P.; Sanguandeekul, R.; Siripatrawan, U. Enhancing effect of nanoemulsion on antimicrobial activity of cinnamon essential oil against foodborne pathogens in refrigerated Asian seabass (Lates calcarifer) fillets. Food Control 2021, 122, 107782. [Google Scholar] [CrossRef]
- Liu, Q.; Gao, Y.; Fu, X.; Chen, W.; Yang, J.; Chen, Z.; Wang, Z.; Zhuansun, X.; Feng, J.; Chen, Y. Preparation of peppermint oil nanoemulsions: Investigation of stability, antibacterial mechanism and apoptosis effects. Colloids Surf. B Biointerfaces 2021, 201, 111626. [Google Scholar] [CrossRef]
- Zheng, H.; Mei, J.; Liu, F.; Chen, L.; Li, F.; Zeng, Q.; Wang, J.J. Preparation and characterization of carvacrol essential oil-loaded halloysite nanotubes and their application in antibacterial packaging. Food Packag. Shelf Life 2022, 34, 100972. [Google Scholar] [CrossRef]
- Rozhina, E.; Batasheva, S.; Miftakhova, R.; Yan, X.; Vikulina, A.; Volodkin, D.; Fakhrullin, R. Comparative cytotoxicity of kaolinite, halloysite, multiwalled carbon nanotubes and graphene oxide. Appl. Clay Sci. 2021, 205, 106041. [Google Scholar] [CrossRef]
- Deb, A.K.; Biswas, B.; Naidu, R.; Rahman, M.M. Mechanistic insights of hexavalent chromium remediation by halloysite-supported copper nanoclusters. J. Hazard. Mater. 2022, 421, 126812. [Google Scholar] [CrossRef] [PubMed]
- Asadi, N.; Naderi, R.; Mahdavian, M. Halloysite nanotubes loaded with imidazole dicarboxylic acid to enhance protection properties of a polymer coating. Prog. Org. Coat. 2019, 127, 375–384. [Google Scholar] [CrossRef]
- Mi, X.; Zhong, L.; Wei, F.; Zeng, L.; Zhang, J.; Zhang, D.; Xu, T. Fabrication of halloysite nanotubes/reduced graphene oxide hybrids for epoxy composites with improved thermal and mechanical properties. Polym. Test. 2019, 76, 473–480. [Google Scholar] [CrossRef]
- Barman, M.; Mahmood, S.; Augustine, R.; Hasan, A.; Thomas, S.; Ghosal, K. Natural halloysite nanotubes /chitosan based bio-nanocomposite for delivering norfloxacin, an anti-microbial agent in sustained release manner. Int. J. Biol. Macromol. 2020, 162, 1849–1861. [Google Scholar] [CrossRef]
- Tang, Y.; Zhou, D.; Zhang, J. Novel polyvinyl alcohol/styrene butadiene rubber latex/carboxymethyl cellulose nanocomposites reinforced with modified halloysite nanotubes. J. Nanomater. 2013, 2013, 542421. [Google Scholar] [CrossRef]
- Zhang, M.; Zhao, W.; Zhang, X.; Li, Z.; Yu, L.; Li, X.; Zhang, Z. Nonfluoride-modified halloysite nanotube-based hybrid: Potential for acquiring super-hydrophobicity and improving flame retardancy of epoxy resin. J. Nanostructure Chem. 2021, 11, 353–366. [Google Scholar] [CrossRef]
- Liu, S.T.; Chen, X.G.; Zhang, S.L.; Liu, X.M.; Zhang, J.J. Preparation and Characterization of Halloysite-Based Carriers for Quercetin Loading and Release. Clays Clay Miner. 2021, 69, 94–104. [Google Scholar] [CrossRef]
- ASTM D3985-24; Standard Test Method for Oxygen Gas Transmission Rate Through Plastic Film and Sheeting Using a Coulometric Sensor. American Society for Testing and Materials: West Conshohocken, PA, USA, 2024.
- Shi, W.; Yan, R.; Huang, L. Preparation and insecticidal performance of sustained-release cinnamon essential oil microemulsion. J. Sci. Food Agric. 2022, 102, 1397–1404. [Google Scholar] [CrossRef]
- Ou, T.; Wu, Y.; Han, W.; Kong, L.; Song, G.; Chen, D.; Su, M. Synthesis of thickness-controllable polydopamine modified halloysite nanotubes (HNTs@PDA) for uranium (VI) removal. J. Hazard. Mater. 2022, 424 Pt A, 127208. [Google Scholar] [CrossRef]
- Pumchan, A.; Cheycharoen, O.; Unajak, S.; Prasittichai, C. An oral biologics carrier from modified halloysite nanotubes. New J. Chem. 2021, 45, 9130–9136. [Google Scholar] [CrossRef]
- Zhang, Y.; Li, Y.; Zhang, Y.; Ding, D.; Wang, L.; Liu, M.; Zhang, F. Thermal behavior and kinetic analysis of halloysite–stearic acid complex. J. Therm. Anal. Calorim. 2019, 135, 2429–2436. [Google Scholar] [CrossRef]
- Shahidi Noghabi, M.; Molaveisi, M. Microencapsulation optimization of cinnamon essential oil in the matrices of gum Arabic, maltodextrin, and inulin by spray-drying using mixture design. J. Food Process Eng. 2020, 43, e13341. [Google Scholar] [CrossRef]
- Klinmalai, P.; Srisa, A.; Laorenza, Y.; Katekhong, W.; Harnkarnsujarit, N. Antifungal and plasticization effects of carvacrol in biodegradable poly(lactic acid) and poly(butylene adipate terephthalate) blend films for bakery packaging. LWT 2021, 152, 112356. [Google Scholar] [CrossRef]
- Hu, J.; Zhang, Y.; Xiao, Z.; Wang, X. Preparation and properties of cinnamon-thyme-ginger composite essential oil nanocapsules. Ind. Crops Prod. 2018, 122, 85–92. [Google Scholar] [CrossRef]
- Yang, N.; Ashton, J.; Kasapis, S. The influence of chitosan on the structural properties of whey protein and wheat starch composite systems. Food Chem. 2015, 179, 60–67. [Google Scholar] [CrossRef]
- Zhou, D.; Pan, Y.; Ye, J.; Jia, J.; Ma, J.; Ge, F. Preparation of walnut oil microcapsules employing soybean protein isolate and maltodextrin with enhanced oxidation stability of walnut oil. LWT-Food Sci. Technol. 2017, 83, 292–297. [Google Scholar] [CrossRef]
- Yang, K.; Liu, A.; Hu, A.; Li, J.; Zen, Z.; Liu, Y.; Tang, S.; Li, C. Preparation and characterization of cinnamon essential oil nanocapsules and comparison of volatile components and antibacterial ability of cinnamon essential oil before and after encapsulation. Food Control 2021, 123, 107783. [Google Scholar] [CrossRef]
- Tornuk, F.; Sagdic, O.; Hancer, M.; Yetim, H. Development of LLDPE based active nanocomposite films with nanoclays impregnated with volatile compounds. Food Res. Int. 2018, 107, 337–345. [Google Scholar] [CrossRef]
- Bagde, P.; Nadanathangam, V. Mechanical, antibacterial and biodegradable properties of starch film containing bacteriocin immobilized crystalline nanocellulose. Carbohydr. Polym. 2019, 222, 115021. [Google Scholar] [CrossRef] [PubMed]
- Tao, D.; Higaki, Y.; Ma, W.; Wu, H.; Shinohara, T.; Yano, T.; Takahara, A. Chain orientation in poly(glycolic acid)/halloysite nanotube hybrid electrospun fibers. Polymer 2015, 60, 284–291. [Google Scholar] [CrossRef]
- Du, M.; Guo, B.; Cai, X.; Jia, Z.; Liu, M.; Jia, D. Morphology and properties of halloysite nanotubes reinforced polypropylene nanocomposites. e-Polymers 2008, 8, 130. [Google Scholar] [CrossRef]

| Sample | LT (%) | WP (g/(m2·24 h)) | OP (cm3/(m2·24 h·0.1 MPa)) |
|---|---|---|---|
| PBAT | 76 ± 1 | 186 ± 2 | 4123 ± 207 |
| CEOs/HNTs/PBAT | 71 ± 3 | 180 ± 1 | 1368 ± 101 |
Disclaimer/Publisher’s Note: The statements, opinions and data contained in all publications are solely those of the individual author(s) and contributor(s) and not of MDPI and/or the editor(s). MDPI and/or the editor(s) disclaim responsibility for any injury to people or property resulting from any ideas, methods, instructions or products referred to in the content. |
© 2025 by the authors. Licensee MDPI, Basel, Switzerland. This article is an open access article distributed under the terms and conditions of the Creative Commons Attribution (CC BY) license (https://creativecommons.org/licenses/by/4.0/).
Share and Cite
Zhou, M.; Tian, Y.; Mo, S.; Zhang, C.; Zhuang, N.; Zheng, H. Cinnamon Essential Oil-Loaded Halloysite Nanotubes Applied in Degradable Film: Characterization and Non-Contact Antimicrobial Activity. Polymers 2025, 17, 1144. https://doi.org/10.3390/polym17091144
Zhou M, Tian Y, Mo S, Zhang C, Zhuang N, Zheng H. Cinnamon Essential Oil-Loaded Halloysite Nanotubes Applied in Degradable Film: Characterization and Non-Contact Antimicrobial Activity. Polymers. 2025; 17(9):1144. https://doi.org/10.3390/polym17091144
Chicago/Turabian StyleZhou, Mingyu, Yuhang Tian, Shuseng Mo, Can Zhang, Ning Zhuang, and Huaming Zheng. 2025. "Cinnamon Essential Oil-Loaded Halloysite Nanotubes Applied in Degradable Film: Characterization and Non-Contact Antimicrobial Activity" Polymers 17, no. 9: 1144. https://doi.org/10.3390/polym17091144
APA StyleZhou, M., Tian, Y., Mo, S., Zhang, C., Zhuang, N., & Zheng, H. (2025). Cinnamon Essential Oil-Loaded Halloysite Nanotubes Applied in Degradable Film: Characterization and Non-Contact Antimicrobial Activity. Polymers, 17(9), 1144. https://doi.org/10.3390/polym17091144






